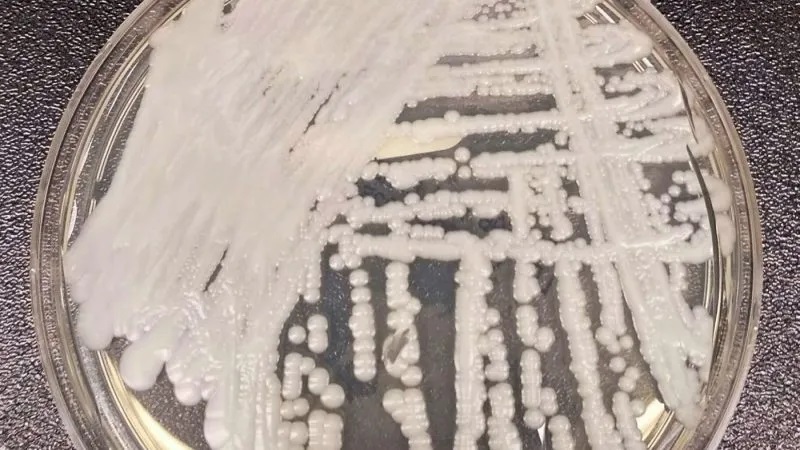
PunjabKesari

Edited By Rohini Oberoi,Updated: 08 Jan, 2026 11:07 AM

अमेरिका में स्वास्थ्य विभाग ने एक बेहद गंभीर हेल्थ अलर्ट जारी किया है। कैंडिडा ऑरिस (Candida auris) नामक एक खतरनाक फंगस (खमीर) तेजी से अमेरिका के अलग-अलग राज्यों में अपने पैर पसार रहा है। विशेषज्ञ इसे 'सुपरबग' कह रहे हैं क्योंकि इस पर आम एंटी-फंगल...
Candida Auris Superbug: अमेरिका में स्वास्थ्य विभाग ने एक बेहद गंभीर हेल्थ अलर्ट जारी किया है। कैंडिडा ऑरिस (Candida auris) नामक एक खतरनाक फंगस (खमीर) तेजी से अमेरिका के अलग-अलग राज्यों में अपने पैर पसार रहा है। विशेषज्ञ इसे 'सुपरबग' कह रहे हैं क्योंकि इस पर आम एंटी-फंगल दवाइयां बेअसर साबित हो रही हैं। कमजोर इम्यूनिटी वाले लोगों के लिए यह फंगस मौत का कारण बन सकता है।
क्या है Candida auris और इसका इतिहास?
यह एक प्रकार का फंगस है जो इंसानी शरीर के खून, घावों और कानों में गंभीर संक्रमण पैदा करता है। इसे पहली बार 2009 में जापान में एक मरीज के कान में पाया गया था। भारत में साल 2014 में इसे सार्वजनिक स्वास्थ्य के लिए एक बड़े खतरे के रूप में पहचाना गया था। सीडीसी (CDC) के ताजा आंकड़ों के अनुसार अब तक अमेरिका के 28 राज्यों में 7,000 से अधिक लोग इसकी चपेट में आ चुके हैं।

यह फंगस इतना खतरनाक क्यों है?
स्वास्थ्य विशेषज्ञ तीन मुख्य कारणों से इससे डरे हुए हैं। यह फंगस 'मल्टी-ड्रग रेजिस्टेंट' है। यानी जिन दवाओं से फंगस का इलाज किया जाता है उनमें से कई इस पर काम ही नहीं करतीं। साधारण लैब टेस्ट में अक्सर इसकी पहचान नहीं हो पाती जिससे इलाज में देरी होती है। यह फंगस अस्पतालों की सतहों (जैसे बेड, उपकरण) पर महीनों तक जिंदा रह सकता है। यह साफ-सफाई और साधारण कीटाणुनाशकों (Disinfectants) से भी आसानी से नहीं मरता।

अमेरिका के किन राज्यों में है अलर्ट?
सीडीसी के मुताबिक यह संक्रमण ओरेगॉन, कैलिफोर्निया, टेक्सास, इलिनोइस, पेंसिल्वेनिया, फ्लोरिडा और जॉर्जिया समेत कुल 28 राज्यों में फैल चुका है। अस्पतालों और नर्सिंग होम में रहने वाले मरीजों को सबसे ज्यादा खतरा बताया गया है।
संक्रमण के लक्षण: कैसे पहचानें?
इसके लक्षण शरीर के प्रभावित हिस्से के आधार पर अलग-अलग हो सकते हैं। कई मरीजों को आईसीयू और वेंटिलेटर तक की जरूरत पड़ रही है।
-
तेज बुखार और कंपकंपी: दवा लेने के बाद भी बुखार का न उतरना।
-
अत्यधिक थकान: शरीर में ऊर्जा की भारी कमी महसूस होना।
-
ब्लड प्रेशर और धड़कन: ब्लड प्रेशर का अचानक गिरना और दिल की धड़कन का तेज होना।
-
कान की समस्या: कान में भारीपन, दर्द या दबाव महसूस होना।
-
कम तापमान: कभी-कभी शरीर का तापमान सामान्य से बहुत कम हो जाना।
बचाव और सावधानी
फिलहाल इस 'सुपरबग' से बचने का सबसे प्रभावी तरीका सावधानी ही है।
-
अस्पतालों में भर्ती मरीजों के पास जाने से पहले और बाद में हाथ अच्छी तरह धोएं।
-
यदि अस्पताल में इलाज के दौरान बुखार या ठंड लगने जैसे लक्षण दिखें तो तुरंत डॉक्टरों को सूचित करें।
-
बुजुर्गों और शुगर या कैंसर जैसी बीमारियों से जूझ रहे लोगों का विशेष ध्यान रखें, क्योंकि उनकी इम्यूनिटी कम होती है।